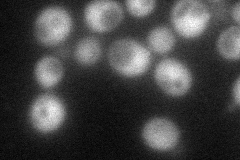
YEL029C

View description
Putative pyridoxal kinase, a key enzyme involved in pyridoxal 5'-phosphate synthesis, the active form of vitamin B6; required for genome integrity; involved in bud-site selection; similarity to yeast BUD17 and human pyridoxal kinase (PDXK)
Localization:
Intensity:
Fold change:
Significance:
-
C’ GFP library in SD

below threshold14.26 -
N' NOP1pr-GFP in SD
cytosol63.7263 -
N' TEF2pr-mCherry in SD

punctate53.6027 -
N' NATIVEpr-GFP in SD

cytosol29.5838 -
N' TEF2pr-VC and Cyto-VN in SD

below threshold26.0327 -
C’ GFP library in SD+DTT

cytosol15.591.09No -
C’ GFP library in SD+H2O2

cytosol17.221.2No -
C’ GFP library in Starvation Media

cytosol19.711.38No -
C’ GFP library on the background of Pup2-DaMP

below threshold -
C’ GFP library on the background of CCT mutant

below threshold16.34211.14486No
